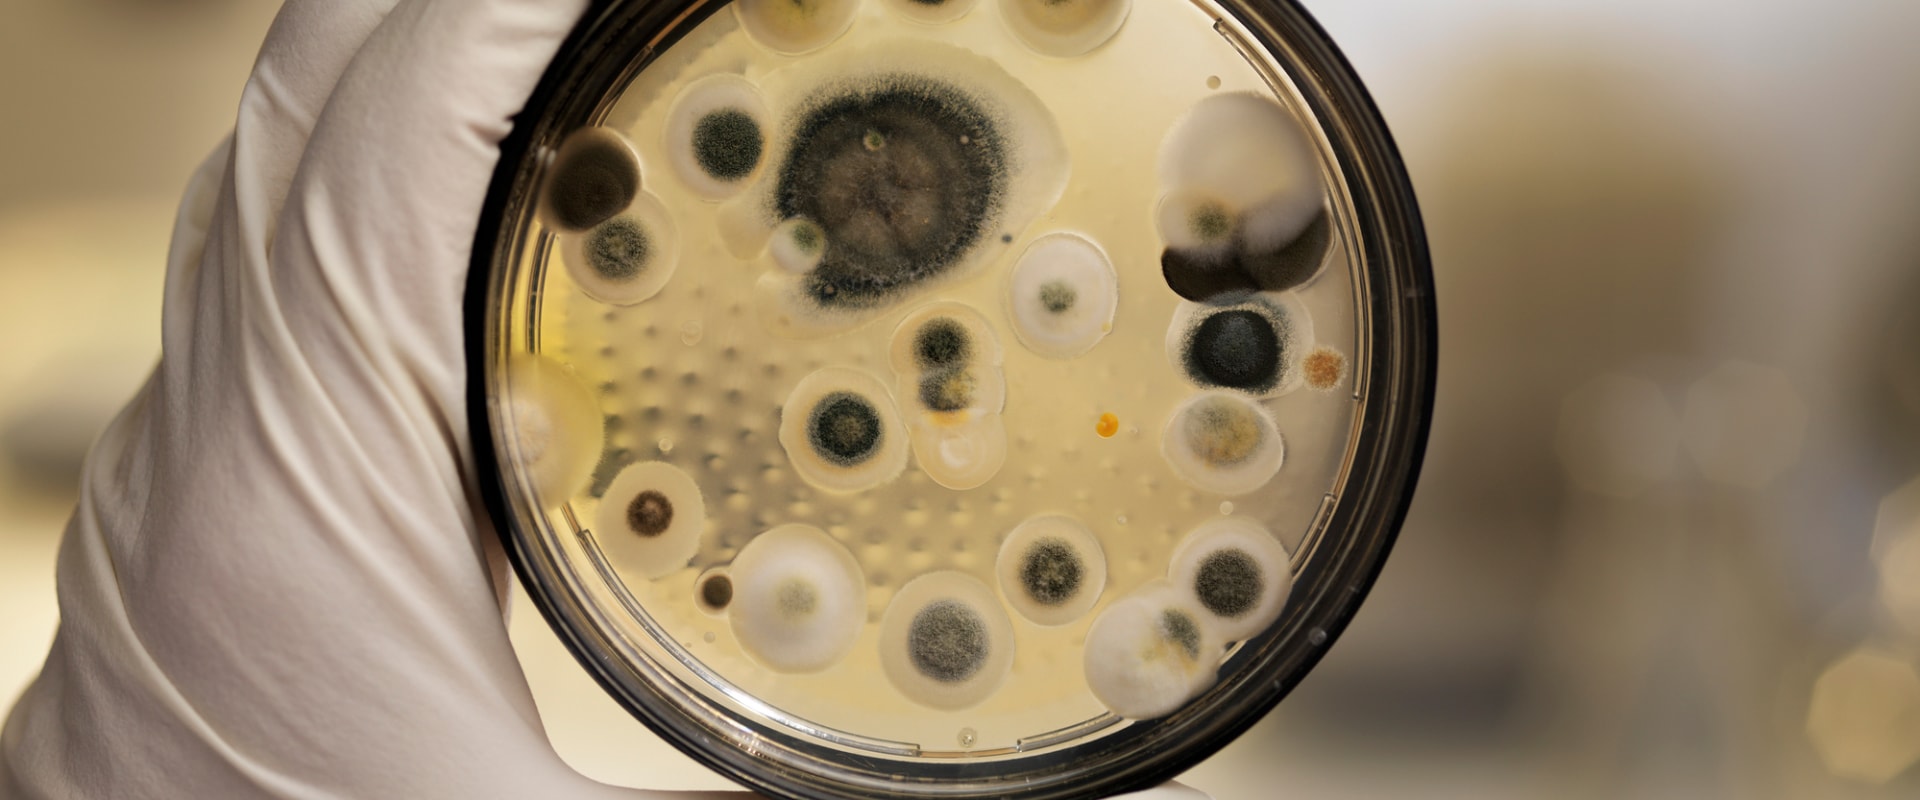

The most common and reliable way to analyze the presence of mold spores in the air is by sampling non-viable air. This is also called “spore trap analysis”. The air will be collected in non-viable media, called cassettes. There are no health standards for acceptable levels of biological agents in indoor air.
We do not recommend taking routine air samples for mold in building air quality assessments. This is because mold concentrations in the air cannot be interpreted in relation to health risks. Of course, if the symptoms are visible and severe, it's best to call professionals to test for mold and remove colonies from your home. If you are collecting direct mold samples using the swab technique, wear gloves and a mask to reduce your exposure to mold.
While there are thousands of species of mold, most homeowners are concerned about Stachybotrys chartarum, commonly known as “toxic mold” or “black mold”. If you're looking for confirmation that your recent mold removal or remediation project has been effective, an air quality test will tell you exactly that (i.e., you don't need to test for mold unless you have a specific reason, as mold infestations can normally be seen or smelled). While a variable mold test can tell you if there are mold spores in a specific room, you'll need to use additional kits if you want to test other rooms in your house. Another reason to consider getting tested is if you can't see or smell mold in your home, but you have unexplained symptoms associated with mold.
In fact, this species of mold is quite rare, but it is one of many molds that produce a high level of mycotoxins (dangerous mold-based chemicals) that can create a hazardous household environment. If the test results are positive for mold spores, it's best to send the test to a laboratory to determine what type of mold it is and how to treat it effectively. If your test determines that there are mold spores in your home, you can send the testing materials to a laboratory that will perform another test to determine what type of mold is present. With the wide range of potential health problems associated with mold, it's important to take steps to detect mold in your home quickly and get rid of it right away.